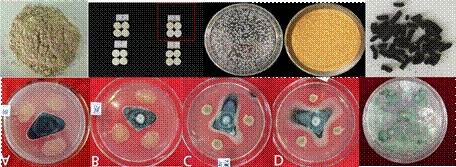

·一、重点实验室简介
“生物农药创制与资源利用自治区高等学校重点实验室(培育)”是由酷爱成人网
多学科交叉融合,并联合内蒙古大有生物肥业股份有限公司、中农绿康(北京)生物技术有限公司共同组建而成。实验室主要任务是为了强化农业生产绿色防控技术提质增效,增强生物农药创制与资源利用的原始创新和集成创新能力,重点攻克生物制药创制的技术瓶颈,开拓新的生物农药资源利用途径,结合新型植保器械,实现农林有害生物绿色防控的理论和关键技术的新突破,促进生物农药由传统技术筛选向现代分子生物学技术定向创制的转变,提高创制效率,创造具有突破性和重大应用前景的优质新型生物农药,从而促进农业生产的减肥、减药与绿色防控相结合的可持续发展,保障农产品产量和品质安全。实验室依托植物保护专业国家级一流本科专业建设点、植物保护一级学科博士学位授权点、作物保护学二级博士点(自设)、植物保护与资源利用专业硕士学位授权点,并常年招聘博士后科研人员。
二、研究团队及学术委员会
实验室现有固定人员25人、流动人员10人,其中具有高级职称的科研人员17人。国家产业体系岗位科学家1人;海外高层次引进人才2人;入选自治区草原英才3人;入选自治区“321”人才工程2人;自治区杰出青年人才培养项目获得者1人。引进优秀博士4人。团队人才结构合理、精干高效。成员中具有高级职称人员占74%,中级职称人员占17%,项目管理人员占9%。
团队中有中国植物病理学会理事1人,中国植物病理学会病毒专业委员会委员1人,中国植物保护学院理事2人,全国植物病理学教学委员会委员2人。中国昆虫学会理事2人、中国昆虫学会蜱螨专业委员会委员1人、中国昆虫学会专业委员会委员1人,中国植保学会生物防治专业委员会委员2人、国际生防组织(IOBC)会员1人。内蒙古昆虫学会理事长1人、内蒙古植物保护学会副理事长2人、中国草学会草地植保专业委员会委员1人。
学术(技术)委员会组成
|
姓 名 |
专业特长 |
职务 |
职称 |
工作单位 |
学术(技术)委员会主任 |
王琦 |
植物微生态学 |
国家增产菌技术研究推广中心主任、中国农业大学植物生态工程研究所所长 |
教授 |
中国农业大学 |
学术(技术)委员会委员 |
姚斌 |
微生物工程 |
中国微生物学会酶工程专业委员会副主任委员 |
研究员/中国工程院院士 |
中国农业科学院 |
马平 |
生物农药 |
所长、中国生物农药与生物防治产业技术创新联盟副理事长 |
研究员 |
河北省农林科学院植物保护研究所 |
张力群 |
植物病害生物防治 |
中国植物保护学会理事 |
教授 |
中国农业大学 |
杨合同 |
微生物资源利用 |
山东省应用微生物重点实验室主任 |
研究员 |
山东省科学院生物研究所 |
王伟 |
生物药物研究与创制 |
上海市植物病理学会副理事长 |
教授 |
华东理工大学 |
钱国良 |
植物病害生物防治 |
中国植物病理学会青年植物病理学家 |
教授 |
南京农业大学 |
王远宏 |
植物病害生物防治 |
院长、中国植物病理学会理事 |
教授 |
天津农学院 |
李子钦 |
植物病理学 |
所长、中国植物病理学会理事 |
研究员 |
内蒙古自治区农牧业科学院 |
周洪友 |
植物病害生物防治 |
院长、中国植物病理学会理事 |
教授 |
酷爱成人网
|
赵明敏 |
植物病理学 |
中国植物病理学会病毒专业委员会与植物与病原物互作专业委员会委员 |
教授 |
酷爱成人网
|
三、研究方向及内容
1.微生物农药创制及其资源利用
建立基于微生物基因组学的菌种资源优异性状新基因发掘技术平台,以重要的功能微生物(包括植保微生物和肥料微生物)性状(促进生长、增产、抗病虫、抗盐、固氮、解磷、解钾、耐旱、耐低温等)作为主要研究方向,利用功能基因组学、生物信息学以及反向遗传学手段,结合高通量测序技术、基因芯片技术、同源重组基因克隆技术,挖掘具有自主知识产权、在农业生产中具有重要应用价值的功能微生物资源,揭示与微生物相关的分子调控网络、代谢通路以及基因相互作用网络。
在此基础上,通过化学、物理诱变、过量表达、基因沉默等手段快速创造各种突变体,应用高通量的基因功能验证体系,明确功能菌株在微生物资源中的数量分布、利用价值与有效利用途径。最终与农业生产相结合,将功能菌株应用于我区主要特色作物马铃薯、向日葵、玉米、小麦、燕麦等重要粮油作物中,实现农作物的绿色无公害生产,提高农业生产效率。
2.昆虫多样性研究与天敌资源的开发利用
基于全区主要农作物的害虫和天敌资源的多样性,针对不同作物的主要害虫,借助比较形态学和基因组学手段,挖掘有害生物的天敌资源多样性;比较不同地理区系的昆虫资源多样性,开发适合本地区不同生态植被和气候特点的特有天敌资源,加强对本地区特有天敌资源的保护和利用,最大限度地发挥昆虫资源在有害生物绿色防控中的优势。
重点研究捕食螨的生物防治作用。立足于本地区特有的捕食螨天敌资源优势,发掘本地优良捕食螨天敌新品种;研究多种捕食螨天敌及与其他生防产品的相互关系及兼容性,天敌与害虫的协同进化及群体互作的生态学机制,开发多种天敌协调应用技术体系;研发捕食螨天敌的大规模扩繁技术、应用技术体系以及推广应用。
基于作物-害虫-天敌三者的关系,研究天敌资源的保护利用、天敌与害虫的协同进化机制、作物-害虫-天敌三者的互作机制、种群爆发的生态机制,为寻找可持续控制害虫的途径和绿色防控技术的开发,奠定前期基础。
3.植物源农药资源及其植物免疫诱抗剂研究
源于植物的农用活性物质的研究与开发,进行杀菌、杀虫生物活性筛选,有效化学成分分析,筛选到的高活性化合物,进行构效分析。开展植物源农药产业化开发及技术成果转化,为创制新型生物源农药提供依据。
基于植物免疫系统,结合植物微生态调控原理,开发以外源生物或分子激活植物体内的免疫系统的新型植物免疫诱抗剂,提高植物抗病力,激发植物代谢系统,促进植物根茎叶的生长及叶绿素的合成,提高作物产量。研究其防治病虫害、促进生长、增产的作用机理和关键技术。对新型植物免疫诱抗剂进一步试验示范推广与产业化进行研究。
4.生物农药活性、剂型及其产业化开发关键技术研究
开展生物农药的杀菌、杀虫、除草生物活性筛选,活性物质有效化学成分分析。获得的高活性化合物的构效分析。开展生物农药产业化开发关键技术,促进技术成果转化,为创制新型生物农药提供依据。
开展生物农药制剂的研发、筛选及应用技术研究,研究不同生物农药剂型应用关键制约因子,确定最佳技术规程。利用自主研发和市场上销售的微生物菌剂和微生态制剂,对自治区主要农林作物、果蔬、花卉上的有害生物进行绿色防控的相关关键技术研究,并进行产业化开发应用。
开展微生物功能肥料(微生态菌剂)在马铃薯、玉米、大豆等大田作物生产中的土壤解磷、解钾、固氮等生物学特性及其促长增产、提质增效机理与关键应用技术研究。
5.新型高效植保器械研发
随着全球各国对环境污染和食品安全的迫切要求,农药绿色化、施药精准化和防控预警化等需求不断凸显,新型高效植保机械与精准减量施药技术是现代植保的必然需求。实验室将通过融入现代计算机技术、智能传感器技术及智能控制技术等,开展新型高效植保机械与精准减量施药技术的研究与应用,针对我区典型农作物,采用高光谱和数字图像信息相融合方法,建立基于光谱特征的机器视觉检测系统;研究目标作物提取算法与视觉定位检测算法;以病虫害作物为检测对象,根据颜色及形态特征,确定目标提取的颜色空间与图像分割方法;应用光谱技术和图像信息融合技术对病虫害进行检测,增强模型通用性,实现病虫害实时识别。
重点解决粮油作物精准变量植保机械与减量施药技术、现代园艺作物管理装备与技术、植保无人机低空低量施药技术以及植保机械与高效施药技术。研究植保喷雾机器人关键技术。结合现代物联网技术、无线传感器网络、伺服控制技术、静电喷雾技术、光谱与图像检测等技术,构建现代温室(大棚)的数字化信息化管理平台。
依据统防统治和绿色植保的理念,建立标准化系统化施药作业技术规范和评价体系,达到节水、节肥、节药目的,减少农药飘失现象,提高农药利用率,满足不同作物不同病虫草害的防治需求。充分发挥植保机械对发展高效、生态、安全的农业保障和支撑作用。
6.农林有害生物绿色防控技术集成与创新
重点研究自治区特色作物马铃薯、燕麦、胡萝卜、荞麦、玉米和林业等有害生物(病、虫、草)的绿色防控技术。研究不同生态区作物上病虫草害的发生和流行规律、有害生物的动态变化趋势及致害机制、作物的抵抗机制及有害生物和作物的互作机制,综合使用农业、物理、生物、生态和分子生物学技术探索有害生物的绿色甚至是有机防控技术体系。注重在原始创新的基础上,加强技术组装集成,利用自主研发生物农药及防治技术,将有效的防控技术集成形成针对某些有害生物的轻简化绿色防控技术体系,并利用推广部门进行示范推广。并对自治区主要农林作物的有害生物进行绿色防控的产业化开发。
四、进展情况及获得成果
内蒙古自治区生物农药与资源利用重点实验室是自治区农业生产创新体系中的重要组成部分,在地方经济和科技进步特别是植物保护技术创新中扮演着非常重要的角色。实验室自创立起,就一直致力于围绕自治区主要农作物病虫草害,以降低化学农药的投入、提高农产品质量和食品安全、有益于地方经济的可持续发展和农民的增产增收为目标,开展基于生物农药的生物防治以及产业化关键技术研究。建立了服务于自治区农业科技创新领域的实验室和成果转化平台,承担重大农业科研成果的基础研究、应用基础研究以及成果的示范、推广和产业化开发任务。开展了人才培养、农业科技信息服务、农民科技培训等工作。
实验室近两年主持国家和自治区级重大科技计划等各类项目共计42项,主持制定标准21项,获得发明专利14件,获得省部级科技奖励11项,发表学术论文85篇(其中SCI 34篇),出版专著13部;近两年,重点实验室建设与运行经费支出共计716.94万元,可以保证提供必要的技术支撑、后勤保障和国内外合作交流的条件。实验室在生物农药与资源利用方面取得了丰硕的成果:
1.拥有丰富的生物农药资源
实验室目前建有生物防治菌种资源库1个、昆虫天敌资源库1个、植物源农业资源库1个。已收集保存各类生物农药资源2000余份。
2.研制成了多个生物农药制剂
针对内蒙古特色作物重要病害研制出高效微生物菌剂4个,分别为15亿CFU/克芽胞杆菌种子处理剂、5亿CFU/克芽胞杆菌粉剂、0.1亿孢子/克木霉菌粉剂、0.1亿孢子/克复合木霉微胶囊菌剂,田间防病效果达42.45%~80.66%。
3.建立了多个生物农药技术研发平台
在国家和自治区项目的资助下,以酷爱成人网
为依托,实验室先后开展了土传病害综合防控技术、马铃薯黄萎病弱毒株筛选、捕食螨天敌的研究与利用、植物抗病毒相关的表观遗传系研究等研究课题;建成了生物农药创制、剂型研发、生物防治、应用技术中试与产业化基地。建立了生物农药药效检测平台、智能化数据分析平台、规模化转化平台、生物农药加工与储藏车间。
4.初步建立了产学研结合的产业化运行体系
实验室与合作公司(中农绿康(北京)生物技术有限公司和内蒙古大有生物肥业股份有限公司)已经形成科技创新主体和成果转化主体,以成果和技术为纽带紧密联合,初步建立了产学研结合的产业化运行体系,推进了技术成果转化为生产力的速度。
五、优秀成果案例
1.围绕自治区特色作物,开展有害生物绿色防控
本实验室围绕内蒙古特色作物,集成合理轮作、抗性品种、农艺措施、生物防治、化肥农药减量增效、生态调控等措施,开展主要有害生物的绿色防控技术研究与应用推广。首次在国内建立了马铃薯和向日葵黄萎病绿色综合防治技术体系;针对向日葵黄萎病,防效可达67.07%~95.22%,向日葵增产8.97%~29.07%;内蒙古马铃薯主产区推广面积426.14万亩,新增效益177379.71万元;燕麦田病虫草害绿色综合防治技术推广面积105.545万亩,增产率15.95%,新增效益8618.80万元。



向日葵、马铃薯与燕麦田有害生物绿色防控示范情况






科研获奖情况
2.促进科技成果转移转化,推进产学研协同创新
本实验室秉承“生态优先、绿色发展”理念,不断促进科技成果转移转化,推进产学研协同创新,成效显著。联合内蒙古大有生物肥业股份有限公司,在双方合作开展的内蒙古自治区科技成果转化项目“微生态制剂的创制及防控马铃薯土传病害的应用”的支持下,研发创制出高效控病增产的微生态制剂产品2份并获得生物肥料登记。
生防微生物筛选与微生态制剂研发


科技成果与发明专利


转化产品登记
3.开展科技服务,助力乡村振兴
本实验室依托呼和浩特市法人特派员团队“酷爱成人网
植物有害生物绿色防控团队”,深入企业和农户进行实地调研,积极实施党建引领,搭建创新平台,开展农技培训,强化科技服务,做出了大量工作,成果卓著。




4.关注人才培养,引导创新创业
目前,本实验室在内蒙古大有生物肥业股份有限公司已建成“酷爱成人网
教学科研实习基地”,开展从本科生、硕士生到博士生各层次的人才培养工作,并不断促进大学生创新创业。截至目前,指导大学生获得“互联网+”大学生创新创业大赛国家级铜奖1项、内蒙古自治区金奖1项、铜奖1项;指导大学生创新创业项目国家级1项、自治区级1项和校级1项。

大学生创新创业获奖

建立教学科研实习基地
5.推动国际交流,建立资源共享
实验室本着“开放、流动、联合、竞争”的运行机制,积极开展对外开放共享服务,已联合10多家单位开展了生物农药相关的应用基础研究,与企业开展全方位、多层次的联合共建,建立问题导向机制,共享实验室的平台开展创新性合作研究。实验室积极寻求国际科技合作,聘请国内外知名专家作为实验室高级技术顾问,并定期开展学术交流、引进客座人员。通过举办农林有害生物绿色防控技术应用推广培训班,组织科研人员参加国际会议,积极邀请国际学者来实验室参观访问,举办学术会议和学术研讨会;研究学科领域存在的问题、发展方向以及实验室的中长期研究课题和主攻的科学技术问题等。目前,已与国内外高校、科研院开展合作开放课题,委托研究和共同攻关,推动生物农药创制的技术革新,从而推动地区和国家经济建设以及社会的发展,为保障自治区农业生产安全、绿色可持续发展做出贡献。
举办国内外重要学术会议或学术论坛
(1)举办会议:2021年全国植物保护学科创新发展高峰论坛。立足“十四五”开局,为发挥植物保护在我国粮食安全优势,实现“双减”战略以及“一带一路”中的战略作用,从而助力脱贫攻坚,实现乡村振兴最终目标。2021.07.31-08.03,呼和浩特,内蒙古,中国。
(2)举办会议:2021全国植物保护草原青年论坛与全国植物保护博士后论坛,促进我国植物保护青年科学家交流和共同发展,2021.07.31-08.01,呼和浩特,内蒙古,中国。
(3)举办会议:组织召开了“第二届农作物连作障碍绿色解决方案技术与经验交流会”,会议以 “解决连作障碍、助力脱贫攻坚”为主题,旨在组织全国从事连作障碍技术研究与推广的科技人员交流破解连作障碍的新思路、新技术及新产品,展示最新绿色解决方案。2020年8月3日至8月6日,呼和浩特,中国。
(4)举办会议:中国植物病理学会病毒专业委员会“植物病毒前沿论坛”,以提升我国植物病毒学和生物技术研究水平,促进学科交流和发展,2019.12.05-12.07,呼和浩特,中国。
(5)举办会议:举办了“第三届作物黄萎病研究专题研讨会”,进一步促进了黄萎病研究与学术交流,有力推动了相关领域专家的协作,积极提升了作物黄萎病研究的影响力。2019.07.30-08.02,呼和浩特,内蒙古,中国。
参加国内外重要学术会议大会报告
(1)Mingmin Zhao(赵明敏), Frida Mesel-Casanova, David San León, Juan Antonio García and Carmen Simón-Mateo. Processing of functional artificial miRNA constructs can notably differ from that of the parental endogenous miRNA.中国植物病理学会病毒与生物技术2018年学术年会,泰安,山东,2018.10,大会报告。
(2)Wang, D.(王东); Meng, H.(孟焕文); Zhou, H.(周洪友), Occurrence and Biocontrol of potato Verticillium wilt in China, 10th Australasian Soilborne Disease Symposium,澳大利亚阿德莱德,2018.9.4-2018.9.7,大会报告。
(3)Mingmin Zhao(赵明敏), Necrotic syndrome associated to the chimera virus carrying a highly structured noncoding RNA. 2nd? Global conference on Plant Science and Molecular Biology,意大利罗马,? 201808,大会报告。
(4)Mingmin Zhao(赵明敏), Application of synthetic trans-acting siRNAs in antiviral resistance. The 13th International Plant Virus Epidemiology Symposium, Avignon, France(法国),201606,大会报告。
(5)孟瑞霞,捕食螨食物链研究中的几个生态学问题,2019年农作物病虫害生物防治学术研讨会,吉林长春,201910,特邀报告。

国内外学术交流照片